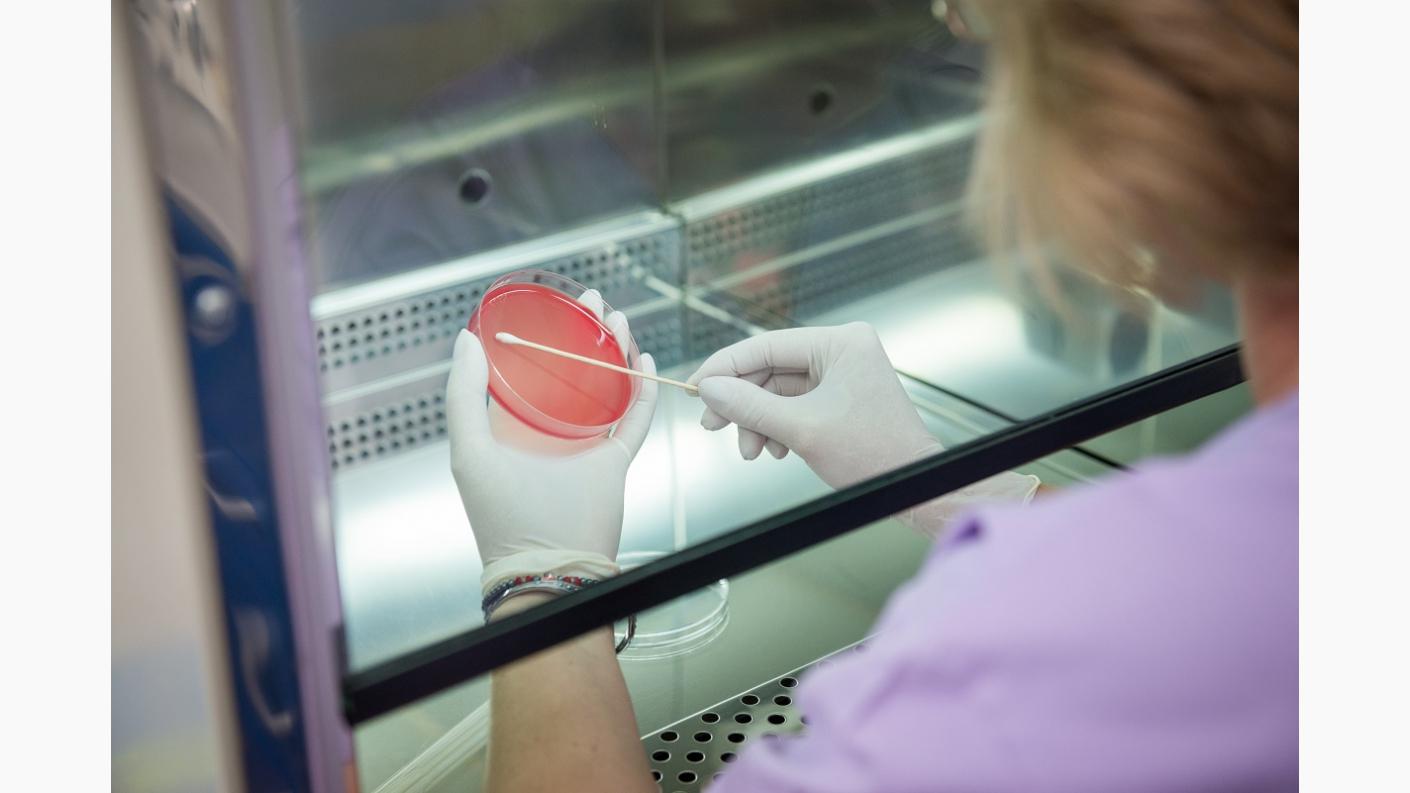

Analize: hemoleucogramă completă, VSH, glicemie, uree, creatinină, TGO, TGP, GGT, bilirubină totală, bilirubină directă, proteine totale, TSH -Hormon de stimulare tiroidiană, colesterol total, HDL colesterol, LDL colesterol + alte analize (consultă lista completă mai jos).
Prevenţia înseamnă înţelepciune. Când vorbim de sănătate ştim cu toţii că este mult mai înţelept să previi o afecţiune decât să o tratezi. Primii paşi pentru detectarea din timp a afecţiunilor la care sunteţi predispuşi constau în efectuarea unor analize medicale alături de un control clinic periodic.
Pachetul „Confort“ - Previi, tratezi şi eşti în siguranţă.
Investigaţiile de laborator incluse sunt:
- hematologie (hemoleucogramă completă),
- markeri de inflamaţie (VSH),
- profil diabet (glicemie),
- funcţia renală (uree, creatinină),
- funcţia hepatică (TGO, TGP, GGT, bilirubină totală, bilirubină directă, proteine totale),
- funcţia tiroidiană (TSH),
- profil lipidic (colesterol total, HDL colesterol, LDL colesterol, trigliceride),
- profil osteo-articular (calciu seric total, calciu ionic seric, factor reumatoid),
- analiza urinii (examen complet urină),
- oligoelemente (fier seric şi magneziu).
Preţ: 500 lei
Etichete